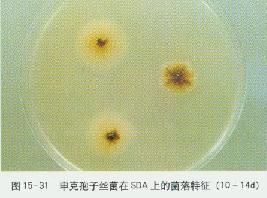
申克孢子絲菌 申克孢子絲菌

申克孢子絲菌分布
申克孢子絲菌(Sporothrixschenckii)在自然界分布廣泛,是土壤、木材、植物的腐生菌。通過皮膚或黏膜感染人,引起孢子絲菌病。
【臨床意義】
本菌主要侵犯皮膚,其特徵為非特異性肉芽腫形成的結節,大多沿淋巴管分布。病原菌通過血流播散,引起全身皮膚出現結節,膿腫。
申克氏孢子絲菌(學名:Sporothrix schenckii)是一種全球常見的溫感二形性真菌,也是Sporothrix屬的唯一物種。
申克孢子絲菌申克孢子絲菌(Sporothrixschenckii)在自然界分布廣泛,是土壤、木材、植物的腐生菌。通過皮膚或黏膜感染人,引起孢子絲菌病。
【臨床意義】
本菌主要侵犯皮膚,其特徵為非特異性肉芽腫形成的結節,大多沿淋巴管分布。病原菌通過血流播散,引起全身皮膚出現結節,膿腫。
申克氏孢子絲菌(學名:)是一種全球常見的溫感二形性真菌,也是屬的唯一物種。
生活環境 感染 診斷與治療肺孢子絲菌病英文名:pulmonarysporotrichosis,是由申克孢子絲菌(sporotrichumschenskii)引起的肺部慢性真菌病,...
症狀 病因 診斷檢查 治療方案 預後孢子絲菌病:由腐生性真菌申克孢子絲菌引起的種感染.通常從受傷皮膚處開始,通過淋巴管播散形成結節,如不治療則形成膿腫和潰瘍.申克孢子絲菌存在於玫瑰,伏牛花...
概述 相關搜尋 參考資料皮膚型孢子絲菌病是由申克氏孢子絲菌所引起的一種慢性深部真菌病。其主要侵犯皮膚、皮下組織及附近淋巴管,亦偶爾累及黏膜和內臟。
基本信息 概述 相關搜尋本病是由申克孢子絲菌引起的皮膚、皮下組織及其附近淋巴管的慢性感染,可引起化膿、潰爛及滲出。潮濕環境和腐爛草木有利於本菌的生長,當皮膚破損時病菌侵入,根據...
臨床表現 診斷 治療 預防孢子菌 是由申克氏孢子絲菌所引起的皮膚、皮下組織及其鄰近淋巴系統的慢性感染。
基本介紹 臨床特點 預防治療克霉唑 克羅確松、抗真菌1號、抗真菌Ⅰ號、氯苯甲咪唑、氯代三苯甲咪唑、氯曲馬唑、氯三苯甲咪唑、氯三苯咪唑、三苯甲咪唑,克霉唑為廣譜抗真菌藥,對多種真菌尤...
物理化學性質 功能作用 藥物名稱 藥物分析 藥代動力學複方克霉唑是一種藥物,主要功效用於皮膚念珠菌病和外陰陰道炎。
基本信息 功用作用 用法及注意